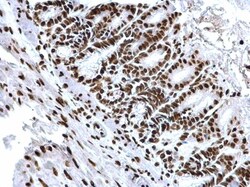
Invitrogen H3K18ac Polyclonal Antibody, ChIP-Verified 100 &mu;L; Unconjugated:Antibodies,

missing translation for 'onlineSavingsMsg'
Learn More
Learn More
Invitrogen™ H3K18ac Polyclonal Antibody, ChIP-Verified


Rabbit Polyclonal Antibody
Brand: Invitrogen™ PA585523
This item is not returnable.
View return policy
Description
Keep as concentrated solution. Positive Control: HeLa. Store product as a concentrated solution. Centrifuge briefly prior to opening the vial. Click here for Master Lot linking information.
Histone H3 is one of the DNA-binding proteins found in the chromatin of all eukaryotic cells. H3 along with four core histone proteins binds to DNA forming the structure of the nucleosome. Histones play a central role in transcription regulation, DNA repair, DNA replication and chromosomal stability. Post translationally, histones are modified in a variety of ways to either directly change the chromatin structure or allow for the binding of specific transcription factors. The N-terminal tail of histone H3 protrudes from the globular nucleosome core and can undergo several different types of post-translational modification that influence cellular processes. These modifications include the covalent attachment of methyl or acetyl groups to lysine and arginine amino acids and the phosphorylation of serine or threonine.
Specifications
| H3K18ac | |
| Polyclonal | |
| Unconjugated | |
| H3C1 | |
| Acetyl H3; Acetyl Histone H3; Acetyl-H3 K18; Acetyl-H3 Lys18; Acetyl-Histone H3 K18; Acetyl-Histone H3 Lys18; B0035.7; CELE_T10C6.12; CG31613; CG31613-PA; CG33803; CG33806; CG33809; CG33812; CG33815; CG33818; CG33821; CG33824; CG33827; CG33830; CG33833; CG33836; CG33839; CG33842; CG33845; CG33848; CG33851; CG33854; CG33857; CG33860; CG33863; CG33866; Dmel\CG31613; Dmel_CG31613; F07B7.10; F07B7.3; F08G2.2; F17E9.13; F35H10.1; F45F2.4; F54E12.5; F55G1.10; H02I12.7; H3; H3 histone; H3 histone family, member A; H3 histone family, member I; H3 histone family, member K; H3 histone family, member L; H3 histone family, member M; H3 histone, family 2; H3 histone, family 3A; H3 histone, family 3B; H3 histone, family 3B (H3.3B); H3 histone, family 3C; H3 K18ac; H3.1-221; H3.1-291; H3.1-I; H3.2; H3.2-221; H3.2-614; H3.2-615; H3.2-616; h3.2a; H3.3A; H3.3B; H3.5; H3/A; H3/b; H3/d; H3/f; H3/i; H3/j; H3/k; H3/l; H3/M; H3/n; H3/o; H3-143; H3-291; H3-3A; H3-3B; H3-53; H3-614; H3a; H3b; H3-B; H3c1; H3c10; H3c11; H3C12; H3C2; H3C3; H3C4; H3C6; H3C7; H3c8; H3f; H3-F; H3F1K; H3F2; H3F3; H3F3A; H3f3b; H3F3C; H3FA; H3FB; H3FC HIST1H3C; H3FD; H3FF; H3FH; H3FI; H3FJ; H3FK; H3FL; H3FM; H3FN; H3g; H3h; H3i; H3K18; H3Lys18ac; h3r; his-12; his-16; his-19; his-21; His3; his-3; His3:CG31613; His3:CG31613-PA; His3:CG33803; His3:CG33806; His3:CG33809; His3:CG33812; His3:CG33815; His3:CG33818; His3:CG33821; His3:CG33824; His3:CG33827; His3:CG33830; His3:CG33833; His3:CG33836; His3:CG33839; His3:CG33842; His3:CG33845; His3:CG33848; His3:CG33851; His3:CG33854; His3:CG33857; His3:CG33860; His3:CG33863; His3:CG33866; his-30; his-33; his-43; his-47; his-51; his-53; his-57; his-61; his-65; his-68; his-7; Hist1; HIST1H3A; HIST1H3B; Hist1h3c; HIST1H3D; HIST1H3E; HIST1H3F; HIST1H3G; hist1h3g.L; Hist1h3h; HIST1H3I; HIST1H3J; hist2h3; HIST2H3A; Hist2h3b; hist2h3c; Hist2h3c1; Hist2h3c2; Hist2h3c2-ps; Hist2h3ca1; Hist2h3ca2; HIST2H3D; histone 1, H3a; histone 1, H3b; histone 1, H3f; histone 1, H3h; histone 2, H3a; histone 2, H3c; histone 2, H3c2; histone 2, H3ca2; Histone 3; histone cluster 1, H3a; histone cluster 1, H3b; histone cluster 1, H3f; histone cluster 1, H3g protein L homeolog; histone cluster 1, H3h; histone cluster 2, H3a; histone cluster 2, H3c; histone cluster 2, H3c2; histone cluster 2, H3c2, pseudogene; histone gene complex 1; Histone H2A; Histone H3; histone H3.1; Histone H3.2; histone H3.3; Histone H3.3C; histone H3.5; Histone H3/a; Histone H3/b; Histone H3/c; Histone H3/d; Histone H3/f; Histone H3/h; Histone H3/i; Histone H3/j; Histone H3/k; histone H3/l; Histone H3/m; histone H3/o; Histone H3K18; histone variant H3.5; K06C4.11; K06C4.3; M32461; PP781; T10C6.12; T23D8.6; XELAEV_18028537mg; ZK131.10; ZK131.6 | |
| Rabbit | |
| Antigen affinity chromatography | |
| RUO | |
| 126961, 260423, 291159, 310678, 319150, 319152, 333932, 360198, 679994, 8350, 8356, 8357, 8358, 852295, 8968, 97114 | |
| Store at 4°C short term. For long term storage, store at -20°C, avoiding freeze/thaw cycles. | |
| Liquid |
| ChIP Assay, Dot Blot, Immunohistochemistry (Paraffin), Immunoprecipitation, Western Blot, Immunocytochemistry | |
| 0.26 mg/mL | |
| PBS with 1% BSA, 20% glycerol and 0.025% ProClin 300; pH 7 | |
| P61830, P68431, P68433, P84228, Q71DI3 | |
| H3C1, H3C10, H3C12, H3C14, H3C15, H3C2, H3C7, HHT1 | |
| Carrier-protein conjugated synthetic peptide surrounding acetyl Lys18 of human Histone H3. The exact sequence is proprietary. | |
| 100 μL | |
| Primary | |
| Human, Mouse, Rat, Yeast | |
| Antibody | |
| IgG |
Product Content Correction
Your input is important to us. Please complete this form to provide feedback related to the content on this product.
Product Title
Spot an opportunity for improvement?Share a Content Correction